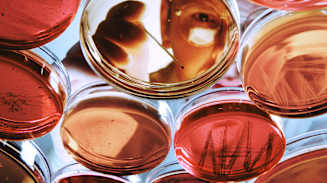
Navigating Risk in Life Sciences: Building Resilience to Support Growth

Collection
The life sciences sector is navigating a convergence of regulatory upheaval, geopolitical tension and rapid market change. In 2025, new US tariffs on drug ingredients, evolving policy positions on drug advertising and vaccine regulations, and aggressive drug price reforms have raised the stakes. At the same time, the expiration of major drug patents across the globe is squeezing margins and intensifying competition, while widespread workforce reductions are challenging organizations’ ability to maintain innovation and operational resilience.
Leading organizations are responding by using risk as a catalyst for growth. By leveraging advanced analytics and alternative strategies, they are optimizing capital allocation and navigating the ever-changing patent landscape to gain a competitive edge.
According to Aon’s Global Risk Management Survey, organizations across the life sciences industry — including biotech, pharmaceutical and medical device companies — identify the following risks as the most critical challenges facing their organizations today:
These risks are deeply interconnected, often compounding one another and amplifying their impact. To better understand what’s at stake, it’s important to examine how some of these key risks are playing out in practice:

Collection
Life sciences supply chains are highly specialized and globally interconnected, with critical dependencies on a small number of suppliers and geographies. Reliance on single-source providers, such as active pharmaceutical ingredients (APIs) and sterile fill-finish capacity in China and India, creates significant vulnerability. Regulatory requirements and the need for highly specialized talent make relocation or diversification a long and costly process — often taking five years or more — which further constrains flexibility.
Recent events have highlighted the fragility of these dependencies. COVID-19-related shortages of APIs and sterile injectables led to widespread disruptions, affecting product availability, patient outcomes and company revenues. These shocks rippled across the industry, demonstrating how a disruption at a single node can have far-reaching consequences.
Supply chain failures often intersect with other top risks, such as business interruption, regulatory change and geopolitical volatility, amplifying their impact. Trade actions such as U.S. Section 232 tariffs and EU initiatives to secure critical medicines are reshaping supply strategies and introducing new uncertainties.
To address these challenges, leading organizations are leveraging advanced analytics, scenario planning and tailored risk financing solutions, including credit insurance and parametric covers, to manage what they can control and ensure continuity even when disruption strikes.
Regulatory and legislative changes remain a defining challenge for life sciences organizations. Companies must navigate evolving trade policies, drug pricing reforms and shifting regulatory requirements across key markets. In the US, reforms and agency staffing cuts are adding complexity, while in Europe, new frameworks like the EMA’s Union list of critical medicines and the proposed EU Critical Medicines Act are reshaping compliance expectations.
Regional divergence in approval processes, such as those of the U.S. Food and Drug Administration, European Medicines Agency and other major markets, complicates global launches and commercialization. Companies must navigate differing regulatory standards and timelines, which can delay market access and increase operational complexity.
Changes to drug pricing and reimbursement rules in major markets have also had a significant impact. For example, recent price controls in Germany and other European countries have led some companies to delay or withdraw product launches due to reduced profitability. Such regulatory shifts can directly affect revenue forecasts and influence long-term investment decisions.
As regulations evolve, companies may find their risk appetite shifting in response to increased uncertainty or new requirements. In these cases, it’s important to reassess and potentially adjust risk financing strategies to ensure they align with changing exposures and organizational objectives.
The life sciences sector is under growing competitive pressure, driven by the rapid expansion of generics, biosimilars and new entrants from technology and digital health. These disruptors are accelerating innovation cycles, eroding market share and forcing traditional players to rethink their strategies.
At the same time, sustaining innovation has become increasingly difficult. Patent expirations and the underperformance of newly launched therapies — particularly in areas such as gene therapy and Alzheimer’s — have placed significant strain on R&D investment. Organizations that fail to deliver commercially viable breakthroughs risk both financial instability and the loss of leadership in critical disease areas.
In response, leading firms are recalibrating their pipelines and deploying predictive analytics to assess early-stage assets more precisely. This helps avoid costly late-stage failures and ensures alignment with shifting regulatory and reimbursement landscapes. Strategic M&A is also playing a critical role, with companies acquiring smaller firms that hold promising assets in development to accelerate innovation and offset pipeline gaps.
Firms are also exploring new approaches to risk financing. Clinical trial failure insurance — though still evolving in terms of pricing and availability — is gaining interest as a way to mitigate the financial impact of unsuccessful trials.
Meanwhile, talent strategy is emerging as a key differentiator. Companies are strengthening R&D and production capabilities by recruiting specialized experts from federal agencies and academic institutions, ensuring they remain competitive in highly regulated, technically demanding environments.

Global Risk Management Survey
Respondents to Aon’s Global Risk Management Survey anticipate that regulatory and geopolitical risks will only grow as global trade and political dynamics evolve. Although factors such as regulatory risk and cyber attacks can be challenging to manage, life sciences organizations are actively finding ways to build resilience and adapt to this evolving environment. The following list highlights the top risks expected to shape the industry over the next three years:
Major project failure has emerged as a critical future concern for life sciences organizations, rising from rank 12 in 2023 to rank six in Aon’s latest survey. This shift reflects the significant time, investment and complexity required to bring new therapies to market. Each product typically requires a decade or more of R&D, followed by rigorous clinical trials and a lengthy regulatory approval process, often with differing requirements across multiple jurisdictions. Setbacks at any stage, whether due to clinical trial failure, regulatory delays or changes, or shifting market needs, can result in substantial financial losses and missed opportunities.
The impact of a single project failure often extends far beyond the immediate product line, affecting investor confidence, cash flow and a company’s ability to fund future innovation. As the sector faces mounting pressure to deliver breakthrough treatments while navigating tighter margins, heightened competition and changes to the regulatory environment, the risk of major project failure is amplified. This has prompted many organizations to consolidate, streamline operations and focus R&D resources on core therapeutic areas.
In this environment, safeguarding large-scale investments and ensuring operational agility are essential. Companies that build resilience into their project pipelines — through advanced analytics, risk transfer and strategic partnerships — will be better positioned to withstand setbacks and capitalize on emerging opportunities.
With extensive experience managing complex technologies, life sciences firms are already integrating AI into business operations. This technological maturity, combined with robust frameworks for safety, compliance and ethics, means that AI is not considered a top 10 current or future risk for the industry. The sector’s familiarity with advanced tools makes the integration of AI a manageable evolution rather than a disruptive revolution.
However, while AI is increasingly used to support business operations, it will take time before more companies are able to embed AI as an effective and efficient tool within their R&D processes. Regulatory bodies and companies alike are still developing the capabilities and governance needed for AI-driven R&D. For now, the most significant impacts of AI are being seen in operational efficiency, with the potential for greater transformation in R&D over the longer term.
Resilient life sciences organizations are taking a more integrated and forward-looking approach to risk — one that connects analytics, financing and strategy. They typically do the following:
Resilient life sciences organizations are leveraging advanced analytics and modeling to quantify their total cost of risk and uncover hidden exposures across supply chains, R&D portfolios and regulatory dependencies. By integrating operational, financial and strategic data, leaders can prioritize risks, allocate capital more effectively and design targeted risk transfer strategies that reflect the complexity of their environment.
To address exposures that traditional insurance may not fully cover, many are turning to alternative risk transfer solutions — such as captives, parametric covers and insurance-linked securities. These approaches unlock new sources of capital, enhance liquidity and improve capital efficiency, particularly in areas such as clinical trial risk, product recall and regulatory delay.
Crucially, these strategies enable organizations to reframe risk management as a value driver. By aligning risk financing with business objectives and embedding risk into capital decisions, boards gain the confidence to fund innovation and expansion — even in uncertain markets. In this way, risk management becomes not just an operational necessity but a lever for growth, efficiency and strategic advantage.

Global Risk Management Survey

Case Study
Supply chain risk assessments help organizations identify operational vulnerabilities. They typically begin with data gathering and integrating supply chain details with broader risk insights. This supports underwriting for property damage and business interruption, helping set appropriate contingent business interruption limits and design effective insurance programs.
A key focus is identifying critical supplier dependencies and assessing how third-party disruptions could affect operations. Financial exposure is estimated by analyzing lost revenue, mitigation costs and disruption duration. Probabilistic modeling may be used to assess event likelihood.
Once established, these models can be adapted to evaluate scenarios such as cyber threats and other nonphysical risks to inform continuity plans and risk financing. Effective assessments also consider regulatory factors affecting recovery timelines and use industry-specific loss data to refine assumptions.
The biggest risk facing life sciences organizations today is no longer disruption itself, but underestimating how interconnected supply chains, data and regulatory landscapes have become. Fragile dependencies and shifting compliance frameworks can quickly cascade across markets, functions and partners, amplifying exposure and complicating recovery. In this environment, being reactive is not an option.
Organizations that embrace innovation, leverage analytics and adopt advanced risk transfer strategies are best positioned to protect their investments and unlock new opportunities.
General Disclaimer
This document is not intended to address any specific situation or to provide legal, regulatory, financial, or other advice. While care has been taken in the production of this document, Aon does not warrant, represent or guarantee the accuracy, adequacy, completeness or fitness for any purpose of the document or any part of it and can accept no liability for any loss incurred in any way by any person who may rely on it. Any recipient shall be responsible for the use to which it puts this document. This document has been compiled using information available to us up to its date of publication and is subject to any qualifications made in the document.
Terms of Use
The contents herein may not be reproduced, reused, reprinted or redistributed without the expressed written consent of Aon, unless otherwise authorized by Aon. To use information contained herein, please write to our team.

Global Risk Management Survey
From business interruption and commodity price volatility to shifting regulations and cyber threats, risks are converging to reshape the operating environment for the natural resources industry. As uncertainty remains the defining challenge of our time, these pressures are driving the need for an increasingly integrated approach to risk.